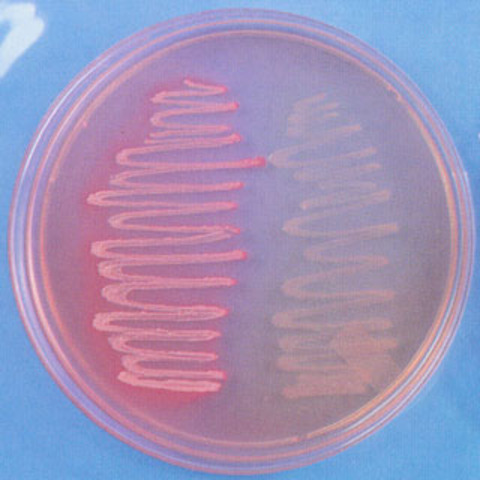
primeras explicaciones de la variación morfológica y fisiológica en bacterias

-
Neisser en 1906 y Rudolf Massini en 1907, en donde analizaron ¿por qué aislamientos de Escherichia coli que no fermentaban lactosa, después de ser sometidos a crecimiento en un medio con lactosa adquirían esta característica? Observaron cambio en el color de las colonias (fermentación) después de una incubación prolongada. Según Massini y Neisser esta habilidad era resultado de mutaciones, y por esta razón estos microorganismos fueron denominados E. coli mutables
-
Se demostró que un cultivo bacteriano es una mezcla de poblaciones bacterianas con diferentes características fisiológicas y cómo el medio ambiente o entorno al cual están sometidas influye en la multiplicación y subsistencia de una población; bajo ciertas condiciones algunos biotipos se pierden o permanecen en minoría, mientras algunas poblaciones se mantienen y adaptan a una condición en particular (Cole & Wright, 1916).
-
Identificó bacterias con diferentes características morfológicas en ultivo de una misma especie bacteriana. Demostró que esa diferencias morfologicas estaban relacionadas con su virulencia. Tiemp después Avery demostró que bacterias no virulentas eran capaces de adquirir esa característica por la captación de material genético de cepas virulentas (transformación)
-
Primer reporte de transformación de Streptococcus pneumoniae no patogénico (colonias rugosas) a patogénico (colonias lisas), cuando las bacterias vivas rugosas fueron expuestas a un extracto de Streptococcus de colonias lisas muertos.
-
Identificaron 2 tipos de enzimas: Adaptativas, las cuales eran sintetizadas cuando la célula estaba en contacto con el sustrato y las constitutivas ya presentes. Representantes importantes: Dienert y Monod: reslataron el papel del sustrato en la fermentación de galactosa. Stephenson y Yudkin: demostraron que la resistencia a antibióticos era causada por la acción enzimas adaptativas
-
Luria y Delbruck se preguntaban sobre la naturaleza de las mutaciones. ¿Eran espontáneas? O por el contrario ¿ocurrían en respuesta a las condiciones ambientales? sí la resistencia era generada por la interacción de la bacteria con el virus (proceso de adaptación), en todas las placas se esperaría un número similar de bacterias resistentes. el número de colonias resistentes variaba de una placa a otra a pesar de que todas fueron inoculadas con el mismo número de bacterias y las mismas condicion
-
Demerec estudió el origen de la resistencia a penicilina en Staphylococcus aureus.
El experimento mostró una amplia variación en el número de bacterias resistentes a penicilina en muestras de cultivos independientes, lo cual confirmaba una interpretación genética del origen de resistencia y la acción de la penicilina como un agente selectivo que inhibe bacterias no resistentes. -
Tatum y Lederberg presentaron evidencia de cómo se transfiere horizontalmente información genética entre bacterias por contacto directo. Este resultado controvertiría la explicación de la resistencia antibiótica desde la selección natural del más apto y retomaría postulados lamarckianos de adaptación
-
En 1959 se demostró que la multirresistencia era fácilmente transferida entre aislamientos de Shigella y E. coli combinando estos microorganismos en un medio cultivo. Esto indujo a la pregunta de ¿cómo se llevaba a cabo la transferencia de multirresistencia de un microorganismo a otro? Para explicar la transferencia de multirresistencia y otras características entre diferentes bacterias, Tatum y Lederberg presentaron evidencia de cómo se transfiere la información genética entre bacterias
-
controlado por un grupo de genes que denominaron operón Lac, el cuál está constituido por 3 genes estructurales: promotor, represor y operador. Estos hallazgos aclararon las dudas expuestas por Stephenson y mostraron que la acción de la galactosidasa es un proceso mucho más complejo que solo podía ser explicado haciendo análisis genético.
Plan projects on a visual timeline
Map milestones, phases, deadlines, and key events in one place so the sequence is easier to see and share. Timetoast is a timeline maker for work, school, research, and stories.